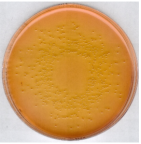
新闻图片5
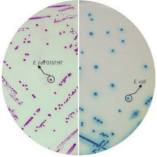
新闻图片6

BUGBUSTER MASTER MIX大肠杆菌总蛋白抽提试剂
¥2056
推荐产品
公司新闻/正文
大肠菌群,肠杆菌科,大肠杆菌?你还傻傻分不清楚吗
10093 人阅读发布时间:2020-06-19 18:16
1 千克的土中约有 4000 万的细菌,一毫升的水中约有一百万个细菌,细菌几乎是无处不在的。细菌从形状上可以大致分为球菌、杆菌和螺旋菌,今天小编将从卫生学的角度讲述杆菌中较为典型的大肠杆菌,对我们日常生活的影响。

要了解大肠杆菌,首先需要了解与它相关的两个概念「肠杆菌科」和「大肠菌群」。
肠肝菌科
肠肝菌科 (Enterobacteriaceae family) 是严格的细菌分类学定义。
肠杆菌科向上承接肠杆菌目 (Enterobacterales order),向下包括近二十个属 (genera),其中包括大家最熟悉的与食品安全风险紧密相关的细菌属类,比如克罗诺菌属 Cronobacter,沙门氏菌属 Salmonella,肠杆菌属 Enterobacter,柠檬酸菌属 Citrobacter,埃希氏菌属 Escherichia, 志贺菌属 Shigella 等等。随着分子生物学的发展,肠杆菌科的分类学一直在更新和变化中,不断有新成员的加入或分离。
生化属性上,肠肝菌科都是短小杆状,兼性厌氧的不生成孢子的革兰氏阴性菌。
大肠菌群
大肠菌群是一个基于源头和致病风险而引申出的,具有重要应用意义的概念,也是重要的食品卫生学指标。
与肠肝菌科不同的是,大肠菌群 coliform 并不是一个细菌分类学概念。也就是说,在正规分类学谱系中,是找不到「大肠菌群」这个定义的。
生化属性方面,它和肠肝菌科相同处很多:短小杆状,兼性厌氧,不生成孢子的革兰氏阴性。但是它与肠杆菌科最.大的区别在于,它能在人体温度 37° C 下发酵乳糖,进而产酸或产气。肠杆菌科中最重要的若干门类因此被排除在大肠菌群集群以外。著名的致病菌属沙门氏, 志贺菌,变形杆菌等,都因为不能踏过乳糖酵解的门槛而被大肠菌群拒之门外。
今天普遍定义的大肠菌群通常包括以下几个属:
肠杆菌属 Enterobacter
柠檬酸菌属 Citrobacter
埃希氏菌属 Escherichia
克雷伯氏菌数 Klebsiella
哈夫尼亚菌属 Hafnia.
大肠菌群的成员都存在于包括人类在内的恒温动物的肠道里,除了肠道排泄物,大肠菌群也会存在于水体,环境土壤和植物中,这些栖息地往往和人类和动物的肠道排泄物紧密相关。因此食品和水质样品中的大肠菌群存在与否和数量高低直接指向粪口污染的可能性,提示相关疾病爆发的风险。
在我国食品安全健康领域相关法规中,大肠菌群地位特别重要,国标将大肠菌群规定为多个食品品类(如肉类,禽类,蛋类,水产品,乳制品,冷冻饮品)的放行指标。
肠杆菌科的细菌学范围比大肠菌群更广泛,但卫生学本质非常相似。肠肝菌科在食物中的存在提示粪便污染的可能性,指向相关致病菌引发的健康担忧,以及食物加速腐坏的高风险。
由于应用习惯和法规制定背景的差异,肠杆菌科在我国食品法规中重要程度一直低于大肠菌群。然而肠杆菌科作为重要卫生学指标,检测要求已经广泛应用于全世界,尤其是欧盟区域的食品生产环境监测和成品放行中。
欧洲食品安全局的欧盟食品微生物标准 (EC) No 2073/2005 将肠杆菌科规定为生产环境和成品放行的监测指标。随着国际间农产品和食品进出口业务不断扩大,欧盟一些国家已对我国出口的食品提出肠杆菌科检测指标的限量要求,且将其作为国际间食品微生物学实验室质量控制和能力验证测试的必测项目之一。
肠杆菌科检测近年来在我国不断推广。除了大型跨国企业将肠杆菌科作为内部企标环境监控和成品及原材料放行的标准以外,2010 年颁布的《粉状婴幼儿配方食品良好生产规范》也把它明确规定为婴配生产环境强制性检测指标,用于监控生产环境消毒卫生措施的有效性。
大肠杆菌
大肠杆菌 E. coli 是大肠菌群的代表菌属。
大多数 E. coli 是非致病的,在动物和人类肠道内正常寄居。小部分特殊血清型的大肠杆菌是条件致病菌,可引发胃肠道感染,严重时发生败血性感染, 血性腹泻和溶血性尿毒综合症等。其中代表性血清型是 E. coli O157:H7/NW。生牛肉是 E. coli O157 爆发最常见的感染源。

培养基:
比较 GB 4789.3-2016 和 GB 4789.41-2016 的培养基附录,我们可以看到两种培养基的主要成分几乎一模一样:蛋白胨提供氮源,碳源,维生素和矿物质;酵母提供微生物生长特别需要的 B 族微生物;胆盐和结晶紫能抑制背景中的革兰氏阳性菌。
两者的区别在于糖类底物的差异:
● VRBGA(结晶紫中性红胆盐葡萄糖琼脂)是 MacConkey 培养基的进化版,底物是葡萄糖,所以不能用来鉴别能酵解乳糖的菌属和不能酵解乳糖的菌属(如沙门氏)。但 VRBG 能支持各种肠杆菌科成员的普遍生长,生长回收率优于 MacConkey 培养基,因此在食品,化妆品和医学微生物检测诊断领域中的应用广泛。
● 典型肠杆菌科在 VRBG 上呈现暗紫红色,菌落带红色晕圈。

Salmonella typhimurium ATCC 14028 VRBG
● VRBA(结晶紫中性红胆盐琼脂)内含乳糖作为唯.一糖类底物,专门用于检测大肠菌群。典型大肠菌群细菌在 VRBA 上呈现紫红色,菌落有时带红色晕圈。非大肠菌群如沙门氏和假单胞菌属的菌落呈现无色或淡黄色。当待测产品中本身含有乳糖以外的糖类时,这些糖类有可能伴随进入培养酵解过程,导致非大肠菌群产生假阳性结果。这种情况需要对菌落进行进一步鉴定。

Escherichia coli ATCC 11775 VRBA

Salmonella typhimurium ATCC 14028 VRBA
VRBA 和 VRBGA 培养基在制备时均不能采用灭菌锅灭菌,加热煮沸就足够了。不适当的加热和灭菌条件有可能引起培养基质量变化。
以上两种培养基的使用应按照相关法律法规和待测参数来选择。大肠菌群和肠杆菌科集群内的大多数菌属成员并不具有致病性,这两者更多作为卫生学指标应用在食品安全检测中。如果要检测其中特定的高风险致病菌如 E. coli O157:H7,则需单独采用相应的检验方法。
GB 4789.36 规定:E. coli O157:H7 分离须同时采用 CT-SMAC 和显色培养基。默克西格玛 ChromoSelect 培养基的显色底物能选择性地被 E. coli O157:H7 分解,菌落呈特异性紫色。非 O157 的 E. coli 及其他大肠菌群呈蓝绿色。


要了解大肠杆菌,首先需要了解与它相关的两个概念「肠杆菌科」和「大肠菌群」。
肠肝菌科
肠肝菌科 (Enterobacteriaceae family) 是严格的细菌分类学定义。
肠杆菌科向上承接肠杆菌目 (Enterobacterales order),向下包括近二十个属 (genera),其中包括大家最熟悉的与食品安全风险紧密相关的细菌属类,比如克罗诺菌属 Cronobacter,沙门氏菌属 Salmonella,肠杆菌属 Enterobacter,柠檬酸菌属 Citrobacter,埃希氏菌属 Escherichia, 志贺菌属 Shigella 等等。随着分子生物学的发展,肠杆菌科的分类学一直在更新和变化中,不断有新成员的加入或分离。
生化属性上,肠肝菌科都是短小杆状,兼性厌氧的不生成孢子的革兰氏阴性菌。
大肠菌群
大肠菌群是一个基于源头和致病风险而引申出的,具有重要应用意义的概念,也是重要的食品卫生学指标。
与肠肝菌科不同的是,大肠菌群 coliform 并不是一个细菌分类学概念。也就是说,在正规分类学谱系中,是找不到「大肠菌群」这个定义的。
生化属性方面,它和肠肝菌科相同处很多:短小杆状,兼性厌氧,不生成孢子的革兰氏阴性。但是它与肠杆菌科最.大的区别在于,它能在人体温度 37° C 下发酵乳糖,进而产酸或产气。肠杆菌科中最重要的若干门类因此被排除在大肠菌群集群以外。著名的致病菌属沙门氏, 志贺菌,变形杆菌等,都因为不能踏过乳糖酵解的门槛而被大肠菌群拒之门外。
今天普遍定义的大肠菌群通常包括以下几个属:
肠杆菌属 Enterobacter
柠檬酸菌属 Citrobacter
埃希氏菌属 Escherichia
克雷伯氏菌数 Klebsiella
哈夫尼亚菌属 Hafnia.
大肠菌群的成员都存在于包括人类在内的恒温动物的肠道里,除了肠道排泄物,大肠菌群也会存在于水体,环境土壤和植物中,这些栖息地往往和人类和动物的肠道排泄物紧密相关。因此食品和水质样品中的大肠菌群存在与否和数量高低直接指向粪口污染的可能性,提示相关疾病爆发的风险。
在我国食品安全健康领域相关法规中,大肠菌群地位特别重要,国标将大肠菌群规定为多个食品品类(如肉类,禽类,蛋类,水产品,乳制品,冷冻饮品)的放行指标。
肠杆菌科的细菌学范围比大肠菌群更广泛,但卫生学本质非常相似。肠肝菌科在食物中的存在提示粪便污染的可能性,指向相关致病菌引发的健康担忧,以及食物加速腐坏的高风险。
由于应用习惯和法规制定背景的差异,肠杆菌科在我国食品法规中重要程度一直低于大肠菌群。然而肠杆菌科作为重要卫生学指标,检测要求已经广泛应用于全世界,尤其是欧盟区域的食品生产环境监测和成品放行中。
欧洲食品安全局的欧盟食品微生物标准 (EC) No 2073/2005 将肠杆菌科规定为生产环境和成品放行的监测指标。随着国际间农产品和食品进出口业务不断扩大,欧盟一些国家已对我国出口的食品提出肠杆菌科检测指标的限量要求,且将其作为国际间食品微生物学实验室质量控制和能力验证测试的必测项目之一。
肠杆菌科检测近年来在我国不断推广。除了大型跨国企业将肠杆菌科作为内部企标环境监控和成品及原材料放行的标准以外,2010 年颁布的《粉状婴幼儿配方食品良好生产规范》也把它明确规定为婴配生产环境强制性检测指标,用于监控生产环境消毒卫生措施的有效性。
大肠杆菌
大肠杆菌 E. coli 是大肠菌群的代表菌属。
大多数 E. coli 是非致病的,在动物和人类肠道内正常寄居。小部分特殊血清型的大肠杆菌是条件致病菌,可引发胃肠道感染,严重时发生败血性感染, 血性腹泻和溶血性尿毒综合症等。其中代表性血清型是 E. coli O157:H7/NW。生牛肉是 E. coli O157 爆发最常见的感染源。

培养基:
比较 GB 4789.3-2016 和 GB 4789.41-2016 的培养基附录,我们可以看到两种培养基的主要成分几乎一模一样:蛋白胨提供氮源,碳源,维生素和矿物质;酵母提供微生物生长特别需要的 B 族微生物;胆盐和结晶紫能抑制背景中的革兰氏阳性菌。
两者的区别在于糖类底物的差异:
● VRBGA(结晶紫中性红胆盐葡萄糖琼脂)是 MacConkey 培养基的进化版,底物是葡萄糖,所以不能用来鉴别能酵解乳糖的菌属和不能酵解乳糖的菌属(如沙门氏)。但 VRBG 能支持各种肠杆菌科成员的普遍生长,生长回收率优于 MacConkey 培养基,因此在食品,化妆品和医学微生物检测诊断领域中的应用广泛。
● 典型肠杆菌科在 VRBG 上呈现暗紫红色,菌落带红色晕圈。

Salmonella typhimurium ATCC 14028 VRBG
● VRBA(结晶紫中性红胆盐琼脂)内含乳糖作为唯.一糖类底物,专门用于检测大肠菌群。典型大肠菌群细菌在 VRBA 上呈现紫红色,菌落有时带红色晕圈。非大肠菌群如沙门氏和假单胞菌属的菌落呈现无色或淡黄色。当待测产品中本身含有乳糖以外的糖类时,这些糖类有可能伴随进入培养酵解过程,导致非大肠菌群产生假阳性结果。这种情况需要对菌落进行进一步鉴定。

Escherichia coli ATCC 11775 VRBA
Salmonella typhimurium ATCC 14028 VRBA
VRBA 和 VRBGA 培养基在制备时均不能采用灭菌锅灭菌,加热煮沸就足够了。不适当的加热和灭菌条件有可能引起培养基质量变化。
以上两种培养基的使用应按照相关法律法规和待测参数来选择。大肠菌群和肠杆菌科集群内的大多数菌属成员并不具有致病性,这两者更多作为卫生学指标应用在食品安全检测中。如果要检测其中特定的高风险致病菌如 E. coli O157:H7,则需单独采用相应的检验方法。
GB 4789.36 规定:E. coli O157:H7 分离须同时采用 CT-SMAC 和显色培养基。默克西格玛 ChromoSelect 培养基的显色底物能选择性地被 E. coli O157:H7 分解,菌落呈特异性紫色。非 O157 的 E. coli 及其他大肠菌群呈蓝绿色。